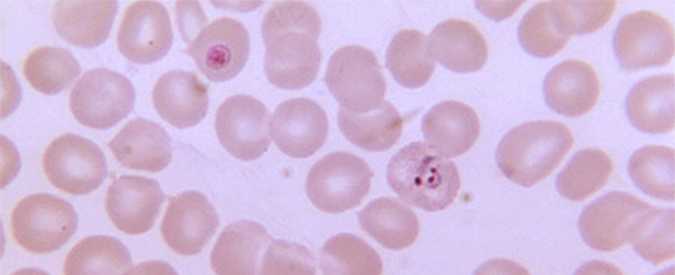
Malaria Drug Resistance Testing Services

Malaria is a mosquito-borne disease caused by a parasite. People with malaria often experience fever, chills, and flu-like illness. Left untreated, they may develop severe complications and die. In 2015 an estimated 212 million cases of malaria occurred worldwide and 429,000 people died, mostly children in the African Region. About 1,700 cases of malaria are diagnosed in the United States each year. The vast majority of cases in the United States are in travelers and immigrants returning from countries where malaria transmission occurs, many from sub-Saharan Africa and South Asia.
Alerts
Blood Banks
How Can I Help?
Quick Links
- CDC Yellow Book 2018: Travel health recommendations New!
- How to Report a Case of Malaria
- Malaria Maps New!
- Red Pages: Malaria-endemic areas by country
- Drugs for Prevention
- Choosing a Drug to Prevent Malaria
- Drugs for Treatment in the U.S.
- Frequently Asked Questions (FAQs)
- Glossary
References and Resources
Programs & Campaigns
The U.S. government’s goal under the PMI Strategy 2015-2020 is to work with PMI-supported countries and partners to further reduce malaria deaths and substantially decrease malaria morbidity, toward the long-term goal of elimination.
PMI Eleventh Annual Report, April 2017
Contact Us
- Centers for Disease Control and Prevention
1600 Clifton Rd
MS A-06
Atlanta, GA 30329-4027 -
- Health care providers needing assistance with diagnosis or management of suspected cases of malaria should call the CDC Malaria Hotline: 770-488-7788 or 855-856-4713 toll-free (M-F, 9am-5pm, eastern time).
-
- Emergency consultation after hours, call: 770-488-7100 and request to speak with a CDC Malaria Branch clinician.
- malaria@cdc.gov
- Page last reviewed: October 18, 2017
- Page last updated: October 18, 2017
- Content source:
ShareCompartir